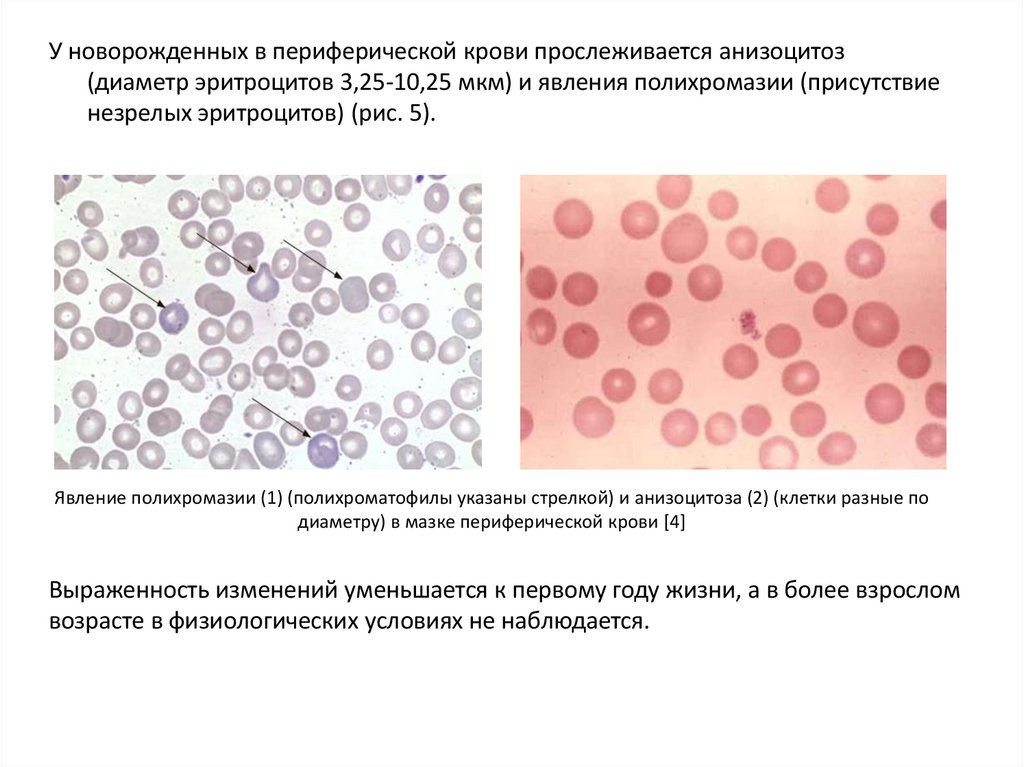

Similar presentations:
Форменные элементы крови, группы крови, переливание крови
1.
Лекция №18Тема: Форменные элементы крови, группы крови,
переливание крови
Дисциплина: нормальная физиология
Лектор: Коноваленко Ю.А.
2.
План лекции:Часть 1. Тема: Форменные элементы крови.
1. Эритроциты.
2. Лейкоциты.
3. Тромбоциты.
Часть 2 Тема: Группы крови.
1. Система АВО
2. Система резус-фактора
3. Переливание крови
3.
1 . Эритроциты (RBC – red blood cells)Строение, свойства и функции соответствуют таковым у взрослых,
однако в детском возрасте имеется ряд особенностей, касающихся
морфологии (рис. 5) [4], и количества клеток (таблица 5) [11].
Нормы для взрослых знать по умолчанию! Обратите внимание на референтные
значения на этом слайде и следующе. Запомните: результат интерпретируется с
учетом возраста и ПОЛА! Что указывается в паспортной информации.
4.
У новорожденных в периферической крови прослеживается анизоцитоз(диаметр эритроцитов 3,25-10,25 мкм) и явления полихромазии (присутствие
незрелых эритроцитов) (рис. 5).
Явление полихромазии (1) (полихроматофилы указаны стрелкой) и анизоцитоза (2) (клетки разные по
диаметру) в мазке периферической крови [4]
Выраженность изменений уменьшается к первому году жизни, а в более взрослом
возрасте в физиологических условиях не наблюдается.
5.
ВозрастКоличество
эритроцитов, Т/л*
1-3 дня 1 нед. 2 нед. 1 мес. 2 мес.
5,3
5,1
4,9
4,2
3,8
3-6
мес.
6 мес. – 2
года
2-11
лет
12 лет
3,8
4,5
4,6
4,6
Изменения количества эритроцитов параллельны изменению
гемоглобина. Транзиторный эритроцитоз в первые дни жизни и количество
молодых эритроцитов является свидетельством интенсивного эритропоэза, как
реакции на недостаточность снабжения плода кислородом. В дальнейшем, в связи с
установлением внешнего дыхания, выработка эритропоэтина снижается, что
приводит к снижению количества эритроцитов [3].
Однако наряду с интенсификацией процессов эритропоэза, в первые дни
жизни происходит разрушение эритроцитов. Эти события необходимы для смены
фетального гемоглобина на гемоглобин взрослых. Разрушение эритроцитов
сопровождается желтухой, которая появляется на 2-3 день после рождения и
исчезает к 7-10 дню. Наиболее низкая концентрация эритроцитов наблюдается в
возрасте 5-6 месяцев [6].
6.
Эритроцитарные индексы – в настоящее времяаналог цветового показателя крови.
7.
Эритроцитарные индексы.8.
RDW-SD (распределение эритроцитов по объёму, стандартное отклонение): 37- 54.
RDW-CV (распределение эритроцитов по объёму, коэффициент вариации):
RDW-CV, %
< 6 мес. - 14,9 - 18,7
> 6 мес. 11,6 - 14,8
Повышение RDW отмечается при значительном разбросе в размерах эритроцитов, что может
быть при железодефицитных анемиях, когда увеличивается количество маленьких эритроцитов
(микроцитов), или при дефиците витамина В12 или фолиевой кислоты, когда повышается число
увеличенных в размере эритроцитов – мегалобластов.
Повышение RDW является одним из наиболее ранних признаков железодефицитной анемии.
Уменьшение среднего объёма эритроцитов при нормальном RDW позволяет заподозрить
талассемию.
Если большинство эритроцитов уменьшены или увеличены, результат RDW может оставаться в
норме.
Патологические причины сниженного RDW неизвестны.
Что может влиять на результат?
Значительное повышение количества ретикулоцитов или лейкоцитов завышает результат RDW.
Важные замечания
Полное представление о внешнем виде и размерах эритроцитов можно получить, если подсчёт
эритроцитарных индексов проводится совместно с оценкой эритроцитов при микроскопии
мазка крови.
9.
2. Лейкоциты – (WBC – white blood cells)Общие характеристики клеток, свойства и функции лейкоцитов соответствуют
таковым у взрослых,
10.
В детском возрасте имеется ряд особенностей, касающихся количестваклеток (таблица. 5) [7] и особенностей лейкоцитарной формулы (табл. 6) [7].
Сразу после рождения количество лейкоцитов повышено (до 20 Г/л),
лейкоцитоз сохраняется на протяжении нескольких недель, после чего
количество лейкоцитов снижается [3].
Среднее число лейкоцитов у детей различного возраста
Возраст
0-10дн.
2 нед. 1 мес. 6 мес.
1 год
2 года
4 года
10,5
10,5
11
9,5
4-8
8-14
лет
лет
8,5
7
Среднее число
лейкоцитов, Г/л
20
10,5
10,5
11.
Лейкоцитоз новорожденных является следствием действиясовокупности факторов. Среди основных выделяют
лейкопоэтическое и лейкомобилизующее действие кортизола.
Источником кортизола может быть как организм матери
(поступает из организма матери при помощи транспортных
белков), так и собственный кортизол плода.
Дополнительными факторами (послеродовыми),
стимулирующими лейкопоэз, являются: «наводнение»
организма бактериальными эндотоксинами, действующими как
через гипоталамо-гипофизарно-надпочечниковую систему, так
и колониестимулирующе на кроветворные клетки костного
мозга. Помимо этого, травматическое раздражение
гипоталамо-гипофизарно-надпочечниковой системы также
способствует развитию нейтрофильного лейкоцитоза [6].
12.
13.
Диагностическим критерием стероидноголейкоцитоза является посуточная убыль лейкоцитов.
После пересечения пуповины поступление стероидов
от матери к плоду прекращается. В это же время происходит
интенсивная инволюция фетальной зоны коры
надпочечников новорождённого, приводящая к снижению
кортизола в крови ребёнка до критического уровня и
соответственно, к резкому ослаблению лейкопоэтического и
лейкоцитозмобилизирующего эффекта кортикостероидов. В
этих условиях быстро отмирает прежняя, короткоживущая
популяция лейкоцитов при заторможенном
восстановительном процессе [6].
14.
Детские особенности лейкоформулы.Сначала в
общечеловеческом
плане:
IG – незрелые
гранулоциты
(преимущественно)
Абсолютные
значения
Относительные
значения
15.
16.
В лейкоцитарной формуле с рождения преобладают нейтрофилы с присутствиеммиело- и метамиелоцитов. К 5-му дню происходит выравнивание количества
нейтрофилов – первый перекрест с последующим нарастанием лимфоцитов. К 5
годам происходит второй перекрест в лейкоформуле, выравнивание числа
нейтрофилов и лимфоцитов (рис. 6). В последующем лейкоформула приобретает
картину взрослого человека (таблица 7) [3].
Возраст
0-10дн.
2 нед.
1 год
4-8 лет
8-14 лет
Нейтрофилы, %
53-82
18-46
26-50
40-50
60-70
Эозинофилы, %
0,6
1,5-6,5
1-5
1-5
1-5
Базофилы, %
0-4
0-2
0-1
0-1
0-1
Лимфоциты, %
5-56
22-69
52-64
34-48
28-42
Моноциты, %
15-34
8,5-28
1-6
1-6
1-6
17.
3. ТромбоцитыТромбоциты – под различными названиями были
известны с XIX века; через 40 лет после их открытия
было подтверждено и описано их участие в
реакциях ТСГ; итальянский ученый Дж. Биццоцеро
описал их морфологию.
Ультраструктура тромбоцита
В неактивном состоянии безъядерные пластинки
округлой формы с диаметром 0,75-1 мкм (в 7 раз
меньше эритроцита).
N-150-400 Г/л (гига/литр)
Наиболее частая патология – тромбоцитопения
30 Г/л – выраженная кровоточивость
100 Г/л – петехиальные кровоизлияния
Продолжительность жизни: 5-11 сут. Образуются в
ККМ; разрушаются в селезенке, легких, печени.
Тромбоцит в сравнении с
эритроцитом
18.
По уточненным данным 1 мегакариоцит образует 3-4 тыс. тромбоцитов в течение 3-5дней, причём отшнуровка происходит не постоянно, а залпами. Поэтому в
миелограмме обнаруживается ОДИН мегакариоцит, окруженный СОТНЯМИ
тромбоцитов. Они представлены в виде шлейфа кометы, вслед за сдвинутым при
производстве мазка мегакариоцитом. В остальные дни тромбоцит «отдыхает»,
накапливая ячейки для образования следующей порции тромбоцитов. За сутки в
организме образуется 175 Г/л тромбоцитов
Тромбоцитарный пул:
•активные 30-40%
•неактивные 60-70%
Тромбопоэтины:
•кратковременного действия – действует,
ускоряя отшнуровку цитоплазмы;
•долговременного действия – способствуют
созреванию мегакариоцитов.
19.
Ультраструктура тромбоцита1. Периферическая зона:
• внешняя оболочка;
• мембрана;
• подмембранное пространство.
2. Зона «золь-гель».
3. Зона органелл.
4. Зона мембран.
+ОКС
20.
Периферическая зона – отвечает вцелом за межклеточное взаимодействие.ОКС (CS) – открытая канальцевая система.
В периферическую зону открывается множество канальцев. Через ОКС в тромбоцит
поступают элементы плазмы крови и выделяются продукты, генерируемые
тромбоцитами.
Выделение тромбоцитарных продуктов через ОКС называется реакцией
высвобождения.
1. Периферическая зона
• внешняя оболочка
Содержит гликопротеины, специфические для
тромбоцитов, как правило, состоит из
нескольких субъединиц и работают в комплексе.
21.
ГП IГП I b – рецептор к фактору FW, необходим
для связывания тр-в с эндотелием
ГП I a
Ia/IIa – рецептор к коллагену
ГП II a
ГП II
ГП II b
ГП III
ГП III a
IIb/IIIa – рецептор для коллагена и
фибриногена, вызывает адгезию
тромбоцитов
ГП IV – стимулирует резистентность к
трипсину и химотрипсину
ГП V – необходим для
осуществления тромбагрегации
ГП VI – необходим для контакта трв со стенкой сосудов и между
собой
22.
1. Периферическмй слой:• внешняя оболочка;
• мембрана
Мембрана периферического слоя состоит из слоя фосфолипидов (ФЛ).
Функции мембраны:
1. ФЛ являются матрицами для белков коагуляционного гемостаза.
2. ФЛ являются субстратом для инициации тромбоцитарных ферментов,
инициирующих продукцию тромбоксана А2, являющегося важнейшим
мощным фактором тромбагрегации.
3. Передают сигналы с поверхности клетки во внутриклеточную среду.
Механизм передачи: При активации тромбоцитов агонист (активатор) связывается
со специфическим рецептором и запускает цепь последовательных событий:
Увеличивается[Ca2+] в цитоплазме результатом этого является феномен
сокращения-расслабления с участием контрактильных белков по типу мышечного
сокращения.
В результате тромбоцит принимает клиновидно-сферическую форму.
Активаторы: серотонин, АДФ, тромбоксаны, коллаген, бактерии и вирусы
23.
2. Зона «золь-гель»Представлена вязким веществом внутри тромбоцита, состоит из белков,
объединенных в волокнистые структуры. В зоне «золь-гель» находится кольцо
из микротрубочек.
При активации тромбоцита микротрубочки сокращаются, смещая при этом
гранулы к центру тромбоцита («централизация гранул»); сжимает их, вызывая
секрецию содержимого через систему ОКС в плазму. Сокращение кольца
микротрубочек позволяет образовывать псевдоподии, что увеличивает их
способность к агрегации.
3. Зона органелл.
Содержит гранулы
Гранулы
Альфа-гранулы
Альфа-гранулы I
Электронно-плотные гранулы
Альфа-гранулы II (содержат
лизосомальные ферменты)
24.
4. Зона мембран.Твёрдая система мембран, состоящая из микротрубочек.
Функция:
• депонирование Са++, необходимого для процессов трансформации
тромбоцита,
• содержит гормональную систему для синтеза простагландинов.
Функции тромбоцитов:
1. Ангиотрофическая.
2. Ангиоспастическая
3. Участие в ТСГ
4. Участие в КГ
5. Принимают участие в системе фибринолиза
6. Защитная функция:
• обладают фагоцитарной активностью;
• содержат IgG
• являются источником лизоцима и бета-лизина
• в стенке тромбоцита обнаружены вещества, вызывающие превращение
нулевых лимфоцитов в Т- и В-лимфоциты (реализуется при травме)
25.
Тромбоцитарные факторы – обозначаются буквой Р (от plateled - пластинка)нумеруются арабскими цифрами; являются эндогенными факторами, обозначаются
арабскими цифрами.
Р1 – тромбоцитарный акселератор - глобулин, идентичный V плазменному
фактору, находится в неактивном состоянии, активируется следами тромбина.
Р2 – акселератор тромбина, ускоряет превращение фибриногена в фибрин.
Р3 – тромбоцитарный тромбопластин – осколок клеточной мембраны.
Р4 – антигепариновый фактор.
Р5 – свёртывающий фактор, идентичный фибриногену.
Р6 – антитромболитический, задерживает фибиринолиз.
Р7 – антитромбопластический фактор.
Р8 – ретрактозим – представляет собой сократительный белок, напоминающий
актомиозин мышечных волокон.
Р9 – серотонин.
Р10 – котромбопластин.
Р11 – фибрин-стабилизирующий фактор.
Р12 – АДФ – активатор агрегации тромбоцитов.
26.
Часть 2. Группы крови1. Система АВО;
2. Система резус-фактора;
3. Переливание крови.
27.
Краткая историческая справка1628 г. — Английский врач Уильям
Гарвей делает открытие о
кровообращении в человеческом
организме. Почти сразу после этого
была предпринята первая попытка
переливания крови.
1667г. - Жан-Батист Дени (фр. JeanBaptiste Denis) во Франции и Ричард
Лоуэр в Англии независимо друг от
друга делают записи об удачных
переливаниях крови от овцы человеку.
Но в последующие десять лет
переливания от животных к людям
были запрещены законом из-за
тяжёлых отрицательных реакций.
28.
1882 г. - Джеймс Бланделл (англ. James Blundell), британскийакушер, проводит первое удачное переливание человеческой
крови пациентке с послеродовым кровотечением. Используя в
качестве донора мужа пациентки, Бланделл взял у него почти
четыре унции крови из руки и с помощью шприца перелил
женщине.
С 1825 по 1830 год Бланделл провел 10 трансфузий, пять из
которых помогли пациентам. Бланделл опубликовал свои
результаты, а также изобрёл первые удобные инструменты для
взятия и переливания крови.
1832 г. — петербургский акушер Андрей Мартынович Вольф
впервые в России успешно перелил роженице с акушерским
кровотечением кровь её мужа и тем самым спас ей жизнь. Вольф
использовал для переливания аппарат и методику, полученную
им от пионера мировой трансфузиологии Джеймса Бланделла.
29.
1840 г. - В колледже Святого Георгия в Лондоне под руководствомБланделла проводится первое удачное переливание крови для
лечения гемофилии.
1867 г. - Английский хирург Джозеф Листер впервые использует
антисептики для предотвращения инфицирования во время
переливаний крови.
1873 - 1880 гг. - Американские трансфузиологии делают попытку
использовать для переливаний молоко — коровье, козье и
человеческое.
1884 г . - Солевые растворы заменяют молоко при переливаниях,
поскольку на молоко возникает слишком много реакций
отторжения.
30.
1900 г. - Карл Ландштейнер (нем. Karl Landsteiner), австрийскийврач, открывает первые три группы крови — A, В и С. Группа С
будет потом заменена на О. За свои открытия Ландштейнер
получил в 1930 г. Нобелевскую премию.
1902 г. — Коллеги Ландштейнера Альфред де Кастелло (итал. Alfred Decastello)
и Адриано Стурли (итал. Adriano Sturli) добавляют к списку групп крови
четвертую — AB.
1907 Ян Янский – окончательно классифицировал кровь по четырем группам –
I, II, III и IV. И это произошло впервые в истории медицины.
1907 г. —Гектоэн (Hektoen) делает предположение о том, что безопасность
трансфузий может быть усовершенствована, если кровь донора и реципиента
проверять на совместимость, чтобы избежать осложнений. Рубен Оттенберг
(англ. Reuben Ottenberg) в Нью-Йорке проводит первое переливание крови с
использованием метода перекрёстной совместимости. Оттенберг также
заметил, что группа крови передаётся по наследству по принципу Менделя и
отметил «универсальную» пригодность крови первой группы.
31.
1908 г. — Французский хирург Аллексис Каррель (фр. AlexisCarrel) разработал способ предотвращения свёртываемости,
пришивая вену реципиента прямо к артерии донора. Этот
метод, известный как прямой метод, или анастомоз, до сих пор
практикуется некоторыми врачами при пересадках. Эта
процедура показала свою непригодность при переливаниях крови, но
развилась как способ трансплантации органов, и именно за неё Каррель
получил Нобелевскую премию в 1912 г.
1914г. —Роджер Ли, врач общественной больницы
Массачусетса, внедряет в лабораторные исследования так
называемое «время свертывания крови Ли-Вайта ». Ещё одно
важнейшее открытие делает Ли, опытным путём доказывая,
что кровь первой группы может быть перелита пациентам с
любой группой, а пациентам с четвёртой группой крови
подходит любая другая группа крови. Таким образом, введены
понятия «универсальный донор» и «универсальный
реципиент».
32.
1914 г. — Изобретены и введены в действие антикоагулянтыдолговременного действия, позволившие консервировать
донорскую кровь, и среди них цитрат натрия.
1915 г. — В госпитале в Нью-Йорке, Ричард Левисон впервые
использует цитрат для замены прямого переливания крови на
непрямое. Несмотря на всю значимость этого изобретения,
цитрат ввели в массовое использование только через 10 лет.
1916 г. — Фрэнсис Рус и Д. Р. Турнер впервые используют
раствор цитрата натрия и глюкозы, позволяющий хранить
кровь в течение нескольких дней после донации. Кровь
начинают хранить в закрытых контейнерах. Во время Первой
мировой войны Великобритания использует мобильную
станцию переливания крови (создателем считается Освальд
Робертсон).
33.
1. Система АВО34.
• Определение групповой принадлежности посистеме АВ0 основано на наличии
естественных агглютиногенов на поверхности
эритроцитов А и В. Тип агглютиногена
наследуется согласно законам Г. Менделя.
• В крови новорожденных агглютининов нет.
Однако затем компоненты пищи, вещества
вырабатываемые микрофлорой кишечника,
способствуют синтезу тех агглютининов,
которых нет в эритроцитах данного человека.
• Агглютинины (альфа, бета) находятся в плазме.
35.
Установлено, чтоагглютинины, являясь
природными антителами,
имеют два центра
связывания, а потому
одна молекула
агглютинина способна
образовать мостик между
двумя эритроцитами. При
этом каждый из
эритроцитов может при
участии агглютининов
связаться с соседним,
благодаря чему возникает
конгломерат (агглютинат)
эритроцитов.
36.
•В крови одного и того же человека не может бытьодноименных агглютиногенов и агглютининов, так как в
противном случае происходило бы массовое склеивание
эритроцитов, что несовместимо с жизнью. Возможны только
четыре комбинации, при которых не встречаются
одноименные агглютиногены и агглютинины, или четыре
группы крови: I — аβ ,II — Аβ, III — Ва, IV — АВ.
37.
•Кроме агглютининов, в плазме, или сыворотке, кровисодержатся гемолизины, их также два вида и они
обозначаются, как и агглютинины, буквами а и β. При
встрече одноименных агглютиногена (на эритроцитах) и
гемолизина (в плазме) наступает гемолиз эритроцитов.
•Действие гемолизинов проявляется при температуре 37—
40 °С. Вот почему при переливании несовместимой крови у
человека уже через 30—40 с наступает гемолиз
эритроцитов.
•При комнатной температуре, если встречаются
одноименные агглютиногены и агглютинины, происходит
агглютинация, но не наблюдается гемолиз.
• В плазме людей с II, III, IV группами крови имеются
антиагглютинины — это покинувшие эритроциты и ткани
агглютиногены. Обозначаются они, как и агглютиногены,
буквами А и В.
38.
39.
2. Система резус-фактора40.
К. Ландштейнер и А.Винер (1940) обнаружили вэритроцитах обезьяны макаки резус антиген, названный
ими резус-фактором. Оказалось, что приблизительно у 85%
людей также имеется этот антиген. Таких людей называют
резус-положительными (Rh+ ). Около 15% людей этот АГ не
имеют и носят название резус-отрицательных (Rh- ).
Известно, что резус-фактор — это сложная система,
включающая более 40 антигенов, обозначаемых цифрами,
буквами и символами. У человека состоит из трех различных
антигенов (агглютиногенов), которые обозначаются С, D и Е
(у D самая высокая агглютинабельная способность).
Система резус не имеет в норме одноименных
агглютининов, но они могут появиться, если резусотрицательному человеку перелить резус-положительную
кровь.
41.
Внимательно читаем вопрос!!Вопрос 2.
Резус-антитела накапливаются в:
1.
2.
3.
4.
плазме крови
лейкоцитах
тромбоцитах
эритроцитах
42.
Резус – конфликт1. При повторном переливании резуснесовместимой крови
2. При резус-несовместимой беременности
43.
Резус-фактор передается по наследству. Если женщина Rh- , амужчина Rh+ , то плод в 50—100% случаев унаследует резусфактор от отца и тогда мать и плод будут несовместимы по
резус-фактору.
44.
Установлено, что при такой беременности плацента обладает повышеннойпроницаемостью по отношению к эритроцитам плода. Последние,
проникая в кровь матери, приводят к образованию антител (антирезус
агглютининов). Подобные процессы происходят и при нарушении
гематоплацентарного барьера. Проникая в кровь плода, антитела вызывают
агглютинацию и гемолиз его эритроцитов.
45.
+ антибонус!!!Тяжелейшие осложнения, возникающие при переливании
несовместимой крови и резус-конфликте, обусловлены не
только образованием конгломератов эритроцитов и их
гемолизом, но и интенсивным внутрисосудистым
свертыванием крови, так как в эритроцитах содержится
набор факторов, вызывающих агрегацию тромбоцитов и
образование фибриновых сгустков. При этом страдают все
органы, но особенно сильно повреждаются почки, так как
сгустки забивают «чудесную сеть» клубочка почки,
препятствуя образованию мочи, что может быть
несовместимо с жизнью
46.
3. Переливание крови47.
48.
49.
http://zdravalt.ru/upload/iblock/d06/797.pdfПРАВИТЕЛЬСТВО РОССИЙСКОЙ ФЕДЕРАЦИИ ПОСТАНОВЛЕНИЕ от 22 июня 2019
г. N 797 ОБ УТВЕРЖДЕНИИ ПРАВИЛ ЗАГОТОВКИ, ХРАНЕНИЯ, ТРАНСПОРТИРОВКИ
И КЛИНИЧЕСКОГО ИСПОЛЬЗОВАНИЯ ДОНОРСКОЙ КРОВИ И ЕЕ КОМПОНЕНТОВ
И О ПРИЗНАНИИ УТРАТИВШИМИ СИЛУ НЕКОТОРЫХ АКТОВ ПРАВИТЕЛЬСТВА
РОССИЙСКОЙ ФЕДЕРАЦИИ
Компоненты донорской крови:
1. Кровь консервированная
2. Кровь консервированная, лейкоредуцированная
………
28. Криопреципитат
29. Гранулоцитный концентрат, полученный методом
афереза.
Условия хранения:
Донорская кровь и эритроцитсодержащие компоненты
донорской крови +2 °C ... +6 °C
50.
Правила переливания крови:https://rg.ru/2013/08/28/donory-dok.html
Приказ Министерства здравоохранения Российской Федерации (Минздрав
России) от 2 апреля 2013 г. N 183н г. Москва "Об утверждении правил
клинического использования донорской крови и (или) ее компонентов"
Главное:
При переливании крови:
1. Определение групповой принадлежности по системе АВО
и резус у реципиента и донорской порции.
2. Проведение пробы на индивидуальную совместимость .
3. Проведение пробы на биологическую совместимость
51.
Пробы на совместимость:https://www.mrckb.ru/files/363.pdf
Приказ Минздрава РФ от 25 ноября 2002 г. № 363 "Об утверждении
Инструкции по применению компонентов крови»
4. Пробы на индивидуальную совместимость крови донора и реципиента
4.1. Двухэтапная проба в пробирках с антиглобулином
4.2. Проба на совместимость на плоскости при комнатной температуре
4.3. Непрямая проба Кумбса
4.4. Проба на совместимость с применением 10% желатина
4.5. Проба на совместимость с применением 33% полиглюкина
6. Биологическая проба
52.
4.2. Проба на совместимость на плоскости при комнатной температуре.На пластинку наносят 2-3 капли сыворотки реципиента и добавляют
небольшое количество эритроцитов с таким расчетом, чтобы соотношение
эритроцитов и сыворотки было 1:10 (для удобства рекомендуется сначала
выпустить через иглу несколько капель эритроцитов из контейнера на край
пластинки, затем оттуда стеклянной палочкой перенести маленькую каплю
эритроцитов в сыворотку).
Далее эритроциты перемешивают с сывороткой, пластинку слегка
покачивают в течение 5 мин, наблюдая за ходом реакции. По истечении
указанного времени в реагирующую смесь можно добавить 1-2 капли
физиологического раствора для снятия возможной неспецифической
агрегации эритроцитов.
Учет результатов. Наличие агглютинации эритроцитов означает, что кровь
донора несовместима с кровью реципиента и не должна быть ему перелита.
Если по истечении 5 мин агглютинация эритроцитов отсутствует, то это
означает, что кровь донора совместима с кровью реципиента по групповым
агглютиногенам.
53.
6. Биологическая пробаТехника проведения биологической пробы заключается в следующем:
однократно переливается 10 мл гемотрансфузионной среды со скоростью
2-3 мл (40-60 капель) в мин, затем переливание прекращают и в течение 3
мин наблюдают за реципиентом, контролируя у него пульс, дыхание,
артериальное давление, общее состояние, цвет кожи, измеряют
температуру тела.
Такую процедуру повторяют еще дважды. Появление в этот период
даже одного из таких клинических симптомов, как озноб, боли в пояснице,
чувство жара и стеснения в груди, головной боли, тошноты или рвоты,
требует немедленного прекращения трансфузии и отказа от переливания
данной трансфузионной среды. Экстренность трансфузии компонентов
крови не освобождает от выполнения биологической пробы. Во время ее
проведения возможно продолжение переливания солевых растворов.
У детей:
Для проведения биологической пробы на совместимость у детей
переливают кровь струйно троекратно с интервалом по 3 минуты в
следующих дозах: детям, до 1 года – 1 мл, до 2 лет – 2 мл, до 5 лет – 5 мл,
до 10 лет – 10 мл, старше 10 лет – 15 мл.
54.
При переливании компонентов крови под наркозом о реакции илиначинающихся осложнениях судят по немотивированному усилению
кровоточивости в операционной ране, снижению артериального давления
и учащению пульса, изменению цвета мочи при катетеризации мочевого
пузыря, а также по результатам пробы на выявление раннего гемолиза. В
таких случаях переливание данной гемотрансфузионной среды
прекращается, хирург и анестезиолог совместно с трансфузиологом
обязаны выяснить причину гемодинамических нарушений.
Если ничто, кроме трансфузии, не могло их вызвать, то данная
гемотрансфузионная среда не переливается, вопрос дальнейшей
трансфузионной терапии решается ими в зависимости от клинических и
лабораторных данных. Биологическая проба, также как и проба на
индивидуальную совместимость, обязательно проводится и в тех случаях,
когда переливается индивидуально подобранная в лаборатории или
фенотипированная эритроцитная масса или взвесь.
55.
Благодарю за внимание!!!56.
Литература:1. Брин, В. Б. Физиология человека в схемах и таблицах [Текст] : учебное пособие / В. Б.Брин. - 2-е изд., доп. и
перераб. . - Ростов н/Д : Феникс, 1999. - 352 с.
2. Гайтон, А. К. Медицинская физиология [Электронный ресурс] : учебник для студентов высших учебных
заведений, обучающихся по направлению "Биология" и специальности "Физиология" : пер. с англ. / А. К.
Гайтон, Дж. Э. Холл. - 2-е изд. на рус. яз. - Электрон. текстовые дан. - М. : Логосфера, 2018. - 1328 с., 1 on-line :
рис., табл. - (Учебник).
3. Галеева, А. В. Клинический анализ крови в практике врача-педиатра / Галеева, А. В., Гайнуллина, Э. А. //
Практическая медицина. – 2009. - №7(39). – С. 16-21.
4. Клетки крови и костного мозга [Текст] : цветной атлас : учебное пособие для студентов медицинских вузов / ред.
Г. И. Козинец. - М. : МИА, 2004. - 203 с.
5. Коробков, А. В. Атлас по нормальной физиологии [Текст] : атлас / А. В. Коробков, С. А. Чеснокова ; ред. Н. А.
Агаджанян. - М. : Высшая школа, 1987. - 351 с.
6. Лифанова, Е. В. Учебное пособие по нормальной физиологии для педиатрического факультета [Текст] / Е. В.
Лифанова, Р. А. Кудрин ; ред. С. В. Клаучек. – Волгоград – 2004. – 171 с.
7. Мосягина, Е. Н. Анемии детского возраста [Текст] : монография / Е. Н.Мосягина. - М. : Медицина, 1969. - 299 с.
8. Нормальная физиология [Текст] : учебник для студентов медицинских вузов по специальностям "Лечебное дело"
и "Педиатрия" / Н. А. Агаджанян [и др.] ; под ред. В. М. Смирнова ; Российский медицинский университет им.
Н. И. Пирогова (М.), кафедра нормальной физиологии. - 3-е изд., перераб. и доп. - М. : Академия, 2010. - 480 с.
9. Практикум по физиологиидля студентов врачебных факультетов [Электронный ресурс] : учебное пособие для
студентов, обучающихся по специальностям "Лечебное дело" и "Педиатрия" / М. А. Медведев [и др.] ; под ред.
М. А. Медведева ; рец.: И. В. Ковалев, Ю. В. Бушов ; Сибирский медицинский университет (Томск). - 3-е изд.,
испр. и доп. - Электрон. текстовые дан. - Томск : Издательство СибГМУ, 2017. - 1 on-line ; 350 с.
10. Савченков, Ю. И. Здоровый ребенок [Текст] : справочник физиологических параметров детского возраста для
врачей педиатров / Ю. И. Савченков, Т. Ф. Венгер. - Красноярск : Издательство Красноярского университета,
1983. - 141 с.
11. Тодоров, Й. Клинические лабораторные исследования в педиатрии [Текст] : пер. с болг. / Й. Тодоров. - 2-е
русское изд. - София : Медицина и физкультура, 1960. - 607 с.
12. Шарабчиев, Ю. Т. Показатели здоровья в цифрах и фактах : справочник / Ю. Т. Шарабчиев, Т. В. Дудина. Минск : Кн. дом, 2004. - 318 с.
13. Zuckerkandl, E. The evolution of hemoglobin / E. Zuckerkandl // Sci. American. – 1965. - № 212. – P. 110-118.

medicine
medicine








